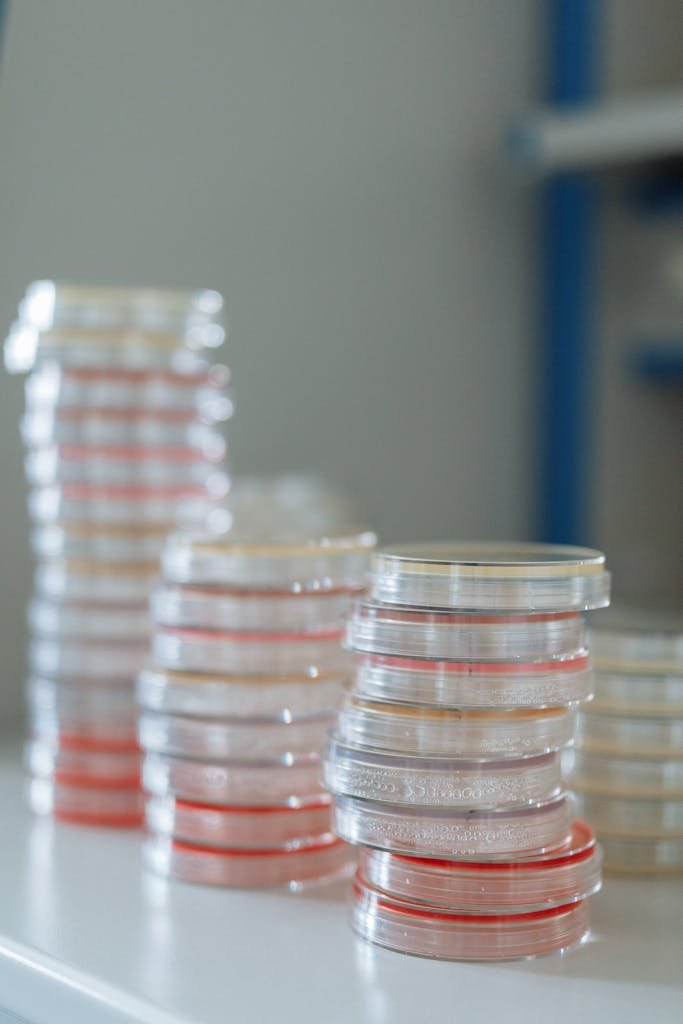
Stacks of sterile petri dishes on a lab bench, highlighting microbiological research essentials.

PRODUCTOS QUE DISTRIBUIMOS, POR LA SEGURIDAD DEL PACIENTE, DEL PERSONAL Y EL CUMPLIMIENTO NORMATIVO
Kit de protección estéril y desechable para el personal de salud. Imprescindible en el área de preparación de mezclas citotóxicas.

- INCLUYE:
- Overol con capucha y cierre.
- Escafandra.
- Botas.
- Cubre bocas.

Ropa y equipos estériles desechables
- Ropa de protección estéril y desechable para profesionales de la salud.





- Equipos quirúrgicos y de procedimientos de enfermería.
Placas de contacto para control microbiológico de cuartos limpios.

- Tipo RODAC y PETRI.
- No requieren refrigeración.
- Incluyen prueba de promoción de crecimiento realizado por un laboratorio tercero autorizado.
DESCUBRE CÓMO PODEMOS AYUDARTE A MEJORAR CON NUESTROS SERVICIOS
Servicios de Consultoría Especializada
Acompañamiento en Proyectos de Centrales de Mezclas y Centros de Infusión: Instalaciones y proceso Farmacoterapéutico
Expertos en procesos (PNOs) seguros y bajo la normatividad para obtención de Licencia Sanitaria.


Capacitación en Oncología Farmacéutica
Formación para profesionales de la salud en Oncología Farmacéutica.
Nuestra oferta de cursos:
- Fabricación de Mezclas Estériles Medicamentosas.
- Buenas prácticas en la Fabricación de Mezclas Estériles Medicamentosas.
- Dispensación de Medicamentos Oncológicos.
- Idoneidad de la Prescripción en Farmacia Oncológica
Auditorías
Auditorías internas: ´Calificación de áreas, procesos y personal. Asesoría para mejora de procesos.
Auditorías a proveedores, apoyando decisiones informadas de contratación.
Reportes técnicos detallados con hallazgos, recomendaciones y planes de acción personalizados.


